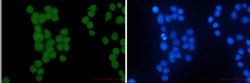
HIPK2 Antibody in Immunocytochemistry (ICC/IF)

Search
Abnova
HIPK2 Recombinant Rabbit Monoclonal Antibody
{{$productOrderCtrl.translations['antibody.pdp.commerceCard.promotion.promotions']}}
{{$productOrderCtrl.translations['antibody.pdp.commerceCard.promotion.viewpromo']}}
{{$productOrderCtrl.translations['antibody.pdp.commerceCard.promotion.promocode']}}: {{promo.promoCode}} {{promo.promoTitle}} {{promo.promoDescription}}. {{$productOrderCtrl.translations['antibody.pdp.commerceCard.promotion.learnmore']}}


Please note: We are reviewing Western blot images included in the antibody testing data in our catalog, including those provided by third parties. Unless expressly labeled or annotated as “raw-unedited”, Western blot images included in the antibody testing data in our catalog may have been edited, optimized or otherwise adjusted for presentation.
产品信息
RAB01434
种属反应
宿主/亚型
Expression System
分类
类型
抗原
偶联物
形式
纯化类型
保存液
内含物
保存条件
运输条件
靶标信息
The HIPK2 gene encodes a member of the homeodomain-interacting protein kinase family, specifically a serine/threonine nuclear protein kinase. HIPK2 plays versatile roles in cellular processes, including transcription regulation, cell proliferation, differentiation, and apoptosis. It interacts with various transcription factors and proteins, contributing significantly to the modulation of gene expression. Notably, HIPK2 is involved in the activation of the tumor suppressor protein p53, with p53-dependent pro-apoptotic activity, positioning HIPK2 as a potential tumor suppressor gene. Recent studies highlight its downregulation in multiple tumor types and its emerging role in cancer biology and therapy. Its expression is subject to quality control mechanisms, including autophosphorylation at serine and threonine sites. Structurally, the crystal structure of HIPK2 reveals unique conformational attributes that contribute to its functionality in different signaling pathways. HIPK2's influence extends to physiological processes, such as fibrosis and central nervous system regulation, indicating its broad biological significance and potential therapeutic applications.
仅用于科研。不用于诊断过程。未经明确授权不得转售。